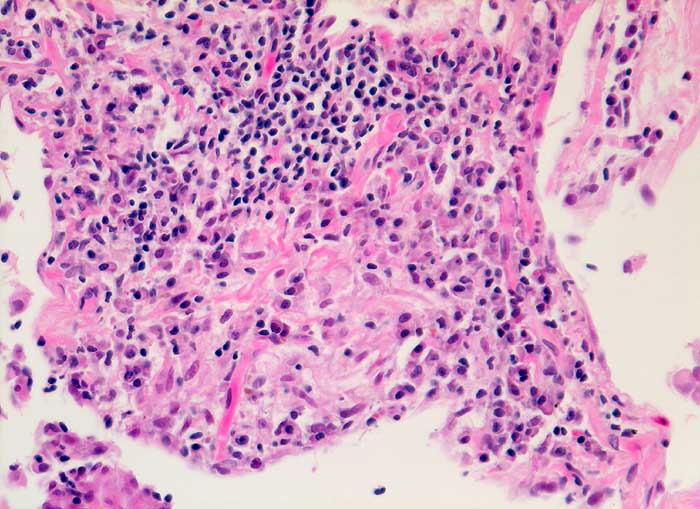

PathoPic – image database / PathoPic ID 5824 - Exogen allergisch Alveolitis
de
Diagnose
Exogen allergisch Alveolitis
Diagnose Gruppe
Systemerkrankung/Immunpathologie
Topographie
Lunge
Topographie Gruppe
Lunge, Mediastinum mit Thymus
Beschreibung
Deutlich ausgeprägte interstitielle lymphoplasmozytäre Entzündung und lockerem intraalveolärem epitheloidzelligem.
Zusatzbefund
Broncho-alveoläre Lavage: Massive Lymphozytose und deutliche Vermehrung der Alveolarmakrophagen mit schaumzelliger Umwandlung. Mässige Eosinophilie und deutliche Vermehrung der Mastzellen.
Klinik
BOOP, Cordarone-Pneumopathie, Alveolarzell-Ca ?
Bilder Typ
Histologie
Vergrösserung
200
Alter
62
Geschlecht
männlich
Datum
Ersteintrag: 13.12.2002
Update: 17.02.2003